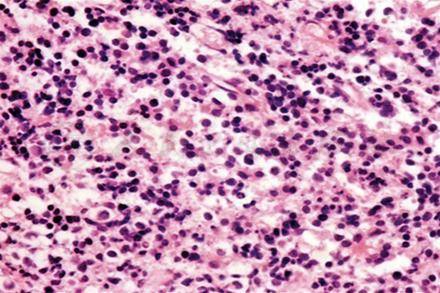

英文名称 :orbital involvement in multiple myeloma
在播散性多发性骨髓瘤中,眼眶软组织受累预示疾病的中晚期,浸润暴发性眼眶受累的病例临床表现很难区分是肿瘤的浸润或附加的机会感染,骨髓瘤可能呈现眼眶蜂窝织炎,它可继发鼻窦受累,或眼眶出血;骨髓瘤可能导致免疫功能损害,也可引起继发于细菌或真菌感染性眼眶。在这样的病例中活检才能显示恶性浆细胞浸润眼眶。
多发性骨髓瘤的瘤细胞分化程度有很大差异,瘤细胞可能异型性大,出现核分裂象(图1)。这些病理表现易与特发性淋巴增生性疾病、未分化肉瘤、弥散性大B细胞淋巴瘤和无色素黑色素瘤相混淆。
大多数多发性骨髓瘤病例要通过眶内肿瘤标本的组织病理、免疫组化染色检查确诊,CD45(部分+)、CD43 (+++)、CD68/KPI(+)(图2)、Mum-1(+)(图3)、KI-67阳性率70%证实诊断,(CD43 慢淋B细胞、T细胞,CD68/KPI 髓细胞、巨噬细胞,CD45淋巴细胞、髓细胞、Mum-1浆细胞分化抗原)。
有时需用PCR技术来帮助诊断,特别困难的病例需骨髓穿刺,其标本再进行组织病理学(图4)和免疫组织化学检查(图5),明确诊断。
图1 组织病理检查见瘤细胞小,形态不规则,部分细胞质呈空泡状 HE×400

图2 瘤细胞CD68/(KPI)表达阳性 IHC×400

图3 瘤细胞Mum-1表达阳性 IHC×400

图4 骨髓穿刺组织标本组织病理检查见骨髓中瘤细胞异型性大,胞核染色深,部分细胞质呈空泡状 HE×300

图5 骨髓穿刺组织标本免疫组化检查,瘤细胞CD138表达阳性IHC×400
病理变化与临床联系:
多发性骨髓瘤的瘤细胞异形性大,出现核分裂多,肿瘤的生物学行为差,瘤细胞生长快,肿瘤迅速长大,故病程短,引起眼睑肿胀,眼球明显前突,眼球活动受限,视功能严重受损。因瘤细胞呈浸润性生长,并累及全身的多个骨髓,患者出现全身无力,发热,衰竭,多处病理性骨折等。
CT扫描能显示受累骨骨质破坏性改变和眼眶内软组织肿块(图6)。

图6 MRI轴位扫描T1WI显示右眼眶尖高信号肿块,斜坡骨质破坏(箭头示)











